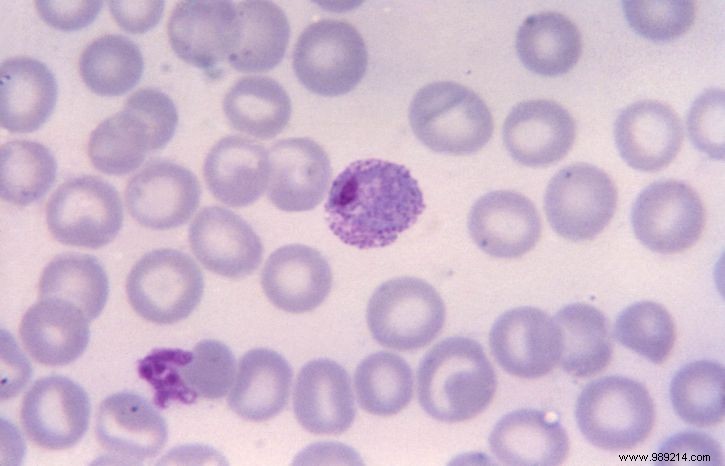
Study: Older Male Cats  Sperm Carries More Genetic Mutations, Impacting Offspring Like in Humans

Just as in humans, aging affects sperm quality in male cats. A U.S. study reveals that repeated cell divisions in sperm production lead to higher rates of mutations, potentially influencing feline offspring health.
While women's biological clocks often get more attention, men—and male animals—are equally impacted. As males age, sperm production becomes prone to errors due to cumulative cell divisions. This accumulation of genetic aberrations can affect offspring, with links to neurodevelopmental disorders like autism and schizophrenia in humans.
Previous research focused on primates, but a study from Indiana University researchers, pre-published on bioRxiv on April 6, 2021, examined domestic male cats. The findings suggest this mutation buildup is common across all mammals—and possibly all sperm-producing animals.
The study found cats' de novo mutation rates slightly lower than humans', but their faster sexual maturation yields comparable results. Analyzing genomes from 11 cat families (fathers, mothers, and kittens), researchers noted 70% of kitten mutations originated from fathers—rising with paternal age. This mirrors humans, where fathers contribute about 80% of such new mutations not present in parents' DNA.
Egg cells pause at late division stages, making large-scale mutations—often chromosomal abnormalities—far more common in sperm. Down syndrome (trisomy 21) exemplifies risks from these mutations. Note: This pre-print awaits peer review.